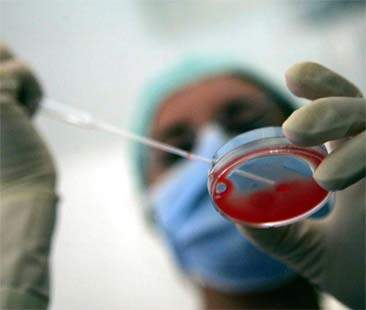
Legge 40 “smontata dal buon senso”. Eterologa, anche la Sicilia è pronta Legge 40 “smontata dal buon senso”. Eterologa, anche la Sicilia è pronta

CATANIA – La sentenza della Consulta che, lo scorso aprile, ha confermato l’illegittimità costituzionale di uno dei capisaldi della legge sulla procreazione medicalmente assistita (n.40/’04), ovvero il divieto di eterologa, ha destato un clamore mediatico che stenta ancora oggi a scemare. La fecondazione eterologa è una tecnica che consente alle coppie sterili di poter procreare utilizzando materiale genetico di un terzo soggetto: qual è il passo successivo alla sentenza?
Lo abbiamo chiesto al Prof. Antonino Guglielmino, direttore del Centro Umr/Hera di Catania.
Lo abbiamo chiesto al Prof. Antonino Guglielmino, direttore del Centro Umr/Hera di Catania.
Professore, il Centro da lei diretto è da sempre in prima fila nella lotta ad una legge, la 40/2004, “smontata dal buon senso”. La sentenza della Consulta che ha fugato ogni dubbio circa l’incostituzionalità del divieto all’eterologa, è anche una vostra vittoria. Si parte a settembre ma previa approvazione di un regolamento da parte della Regione?
“Prima ancora che il nostro Centro, i veri protagonisti della duplice vittoria che ha portato al radicale cambiamento della legge 40, sono i pazienti e l’Associazione Hera. I dubbi di legittimità costituzionale sono stati sollevati da diversi tribunali italiani ma sulla base delle decine dei ricorsi presentati dalle coppie dell’Associazione. Con queste modifiche alla legge 40 sono stati ristabiliti diritti e buone pratiche mediche per le coppie italiane. Per quanto riguarda il Centro che dirigo è pronto, ormai da tempo, ad eseguire la cure cosiddette eterologhe con donazione di gameti, seguendo le norme indicate dalla Corte Suprema, dalle direttive europee recepite dall’Italia e dalle Linee Guida presentate dalle società scientifiche italiane e internazionali. Se la Regione siciliana attraverso l’assessore Borsellino produrrà un atto legislativo, di regolamentazione e normalizzazione delle storture e delle anomalie croniche nell’assistenza alle coppie siciliane, sarà il benvenuto. Dopo che la Corte ha riconosciuto il diritto alle coppie di poter autodeterminarsi nella scelta di costituire una famiglia con figli e considerare questa scelta incoercibile, il passo successivo che affronteremo sarà il riconoscimento di questo diritto attraverso l’inserimento a 360 gradi della Riproduzione assistita nel Sistema Sanitario e nei LEA (Livelli Essenziali di Assistenza) sia a livello Regionale che Nazionale”.
“Prima ancora che il nostro Centro, i veri protagonisti della duplice vittoria che ha portato al radicale cambiamento della legge 40, sono i pazienti e l’Associazione Hera. I dubbi di legittimità costituzionale sono stati sollevati da diversi tribunali italiani ma sulla base delle decine dei ricorsi presentati dalle coppie dell’Associazione. Con queste modifiche alla legge 40 sono stati ristabiliti diritti e buone pratiche mediche per le coppie italiane. Per quanto riguarda il Centro che dirigo è pronto, ormai da tempo, ad eseguire la cure cosiddette eterologhe con donazione di gameti, seguendo le norme indicate dalla Corte Suprema, dalle direttive europee recepite dall’Italia e dalle Linee Guida presentate dalle società scientifiche italiane e internazionali. Se la Regione siciliana attraverso l’assessore Borsellino produrrà un atto legislativo, di regolamentazione e normalizzazione delle storture e delle anomalie croniche nell’assistenza alle coppie siciliane, sarà il benvenuto. Dopo che la Corte ha riconosciuto il diritto alle coppie di poter autodeterminarsi nella scelta di costituire una famiglia con figli e considerare questa scelta incoercibile, il passo successivo che affronteremo sarà il riconoscimento di questo diritto attraverso l’inserimento a 360 gradi della Riproduzione assistita nel Sistema Sanitario e nei LEA (Livelli Essenziali di Assistenza) sia a livello Regionale che Nazionale”.
Concorda con la linea del ministro Lorenzin che sottolinea l’assoluta necessità di un atto legislativo parlamentare oppure ritiene che non esista alcun “vuoto normativo”?
“Sono stati centinaia i giuristi che hanno firmato un appello in cui si afferma l’inesistenza di vuoto normativo per l’applicazione corretta e sicura dell’eterologa in Italia. Questa constatazione oltre ad essere chiaramente espressa nella Sentenza 162 della Corte Costituzionale è stata confermata dal Presidente della stessa Corte Tesauro in un’intervista al Messaggero di qualche settimana fa e ulteriormente confermata con la delibera della Regione Toscana in cui si dà il via libera ai Centri Toscani ad eseguire le cure eterologhe. Infine, ci sono le due sentenze del Tribunale di Bologna del 14 agosto in cui si ordina a due Centri emiliani di eseguire l’eterologa, confermando esplicitamente l’assenza di vuoto normativo. Il ministro Lorenzin ha assunto una posizione di contrarietà, in quanto non accetta l’eliminazione del divieto all’eterologa apportata dalla sentenza della Corte costituzionale. Ha espresso questa sua volontà, tra minacce di interventi dei NAS nei Centri di Riproduzione Assistita e la necessità di una nuova legge, con l’obiettivo di bloccare e affossare la possibilità alle coppie che necessitano della donazione dei gameti nel nostro Paese. Il ministro, invece, potrebbe più facilmente e velocemente procedere con semplici atti amministrativi ed emanare le Linee Guida (scadute da tre anni) che le Società Scientifiche hanno già preparato e presentato. Si tratta solamente di buona volontà e di buon senso. Fino a quando si ragionerà in termini ideologici e non si guarderà in faccia la sofferenza delle coppie che in questi dieci anni sono state costrette a migrare all’estero a costi esagerati, temi come l’eterologa avranno percorsi difficili e sofferti”.
“Sono stati centinaia i giuristi che hanno firmato un appello in cui si afferma l’inesistenza di vuoto normativo per l’applicazione corretta e sicura dell’eterologa in Italia. Questa constatazione oltre ad essere chiaramente espressa nella Sentenza 162 della Corte Costituzionale è stata confermata dal Presidente della stessa Corte Tesauro in un’intervista al Messaggero di qualche settimana fa e ulteriormente confermata con la delibera della Regione Toscana in cui si dà il via libera ai Centri Toscani ad eseguire le cure eterologhe. Infine, ci sono le due sentenze del Tribunale di Bologna del 14 agosto in cui si ordina a due Centri emiliani di eseguire l’eterologa, confermando esplicitamente l’assenza di vuoto normativo. Il ministro Lorenzin ha assunto una posizione di contrarietà, in quanto non accetta l’eliminazione del divieto all’eterologa apportata dalla sentenza della Corte costituzionale. Ha espresso questa sua volontà, tra minacce di interventi dei NAS nei Centri di Riproduzione Assistita e la necessità di una nuova legge, con l’obiettivo di bloccare e affossare la possibilità alle coppie che necessitano della donazione dei gameti nel nostro Paese. Il ministro, invece, potrebbe più facilmente e velocemente procedere con semplici atti amministrativi ed emanare le Linee Guida (scadute da tre anni) che le Società Scientifiche hanno già preparato e presentato. Si tratta solamente di buona volontà e di buon senso. Fino a quando si ragionerà in termini ideologici e non si guarderà in faccia la sofferenza delle coppie che in questi dieci anni sono state costrette a migrare all’estero a costi esagerati, temi come l’eterologa avranno percorsi difficili e sofferti”.
Cosa pensa del decreto del 26 ottobre 2012 riconfermato dall’assessore Borsellino e del paradosso rappresentato dai rimborsi della Regione siciliana previsti solo per le coppie infertili che decidono di curarsi fuori dalla Sicilia? Tale decreto non trova sia al di fuori di ogni logica?
“Questa rappresenta una delle anomalie più gravi nel sistema assistenziale alle coppie infertili in Sicilia. Già denunciata nel Piano Sanitario Regionale 2011-2013 si evidenziava che oltre 2.000 trattamenti su coppie siciliane (circa il 40% del totale dei 5.300 trattamenti eseguiti alle nostre coppie) ogni anno cercano trattamenti riproduttivi assistiti in altre regioni. La ragione è semplice, la coppia siciliana se chiede di essere curata in Sicilia deve pagare di tasca propria (oltre il 90% dei trattamenti vengono eseguiti nel privato), se invece migra al nord la regione siciliana paga il trattamento alla regione ospitante in mobilità passiva. Tutti sanno che la Pma è un trattamento fuori dai LEA e nella nostra regione nonostante i pagamenti alle altre regioni siano impropri e poco chiari ( questo sistema è stato definito dal Presidente della Commissione Sanità del Parlamento Siciliano Pippo Di giacomo “Una truffa da galera”), si continua a preferire pagare le regioni furbe del Nord, anzichè creare un DRG regionale come altre regioni italiane ed evitare che le nostre coppie vadano in giro per l’Italia con gravi disagi familiari, perdendo settimane di lavoro e spendendo in modo improprio denaro pubblico. Ad alcune regioni del Nord la Regione siciliana rimborsa oltre 5.000 euro per trattamento”.
“Questa rappresenta una delle anomalie più gravi nel sistema assistenziale alle coppie infertili in Sicilia. Già denunciata nel Piano Sanitario Regionale 2011-2013 si evidenziava che oltre 2.000 trattamenti su coppie siciliane (circa il 40% del totale dei 5.300 trattamenti eseguiti alle nostre coppie) ogni anno cercano trattamenti riproduttivi assistiti in altre regioni. La ragione è semplice, la coppia siciliana se chiede di essere curata in Sicilia deve pagare di tasca propria (oltre il 90% dei trattamenti vengono eseguiti nel privato), se invece migra al nord la regione siciliana paga il trattamento alla regione ospitante in mobilità passiva. Tutti sanno che la Pma è un trattamento fuori dai LEA e nella nostra regione nonostante i pagamenti alle altre regioni siano impropri e poco chiari ( questo sistema è stato definito dal Presidente della Commissione Sanità del Parlamento Siciliano Pippo Di giacomo “Una truffa da galera”), si continua a preferire pagare le regioni furbe del Nord, anzichè creare un DRG regionale come altre regioni italiane ed evitare che le nostre coppie vadano in giro per l’Italia con gravi disagi familiari, perdendo settimane di lavoro e spendendo in modo improprio denaro pubblico. Ad alcune regioni del Nord la Regione siciliana rimborsa oltre 5.000 euro per trattamento”.
Diagnosi preimpianto – L’altra anomalia della legge sulla Pma
Il dubbio di legittimità costituzionale non riguardava solo l’eterologa ma un altro dei capisaldi della legge 40 , ovvero il divieto di diagnosi preimpianto per le coppie non sterili ma portatrici di malattie genetiche. Cosa ne è stato di quest’altra incongruenza della norma sulla procreazione assistita?
“Con la Sentenza della Corte costituzionale 151 del 2009 abbiamo ottenuto di poter eseguire la diagnosi genetica di preimpianto sugli embrioni prima di essere trasferiti in utero. Per i siciliani questa opportunità ha un valore particolare in quanto il gene della talassemia è largamente presente nella nostra Isola. Fino ad oggi solamente le coppie infertili/sterili e contemporaneamente portatrici di un gene malato possono accedere alla diagnosi preimpianto. La questione è ancora una volta nelle mani della Corte costituzionale, siamo in attesa, si spera prima della fine dell’anno, di una nuova sentenza che corregga quest’altra anomalia consentendo a tutte le coppie fertili e infertili portatrici di malattie genetiche di poter accedere alla diagnosi preimpianto ed evitare di dover scegliere tra due drammi, far nascere un bambino geneticamente malato grave o abortire per interrompere la gravidanza dopo la diagnosi prenatale”.
“Con la Sentenza della Corte costituzionale 151 del 2009 abbiamo ottenuto di poter eseguire la diagnosi genetica di preimpianto sugli embrioni prima di essere trasferiti in utero. Per i siciliani questa opportunità ha un valore particolare in quanto il gene della talassemia è largamente presente nella nostra Isola. Fino ad oggi solamente le coppie infertili/sterili e contemporaneamente portatrici di un gene malato possono accedere alla diagnosi preimpianto. La questione è ancora una volta nelle mani della Corte costituzionale, siamo in attesa, si spera prima della fine dell’anno, di una nuova sentenza che corregga quest’altra anomalia consentendo a tutte le coppie fertili e infertili portatrici di malattie genetiche di poter accedere alla diagnosi preimpianto ed evitare di dover scegliere tra due drammi, far nascere un bambino geneticamente malato grave o abortire per interrompere la gravidanza dopo la diagnosi prenatale”.